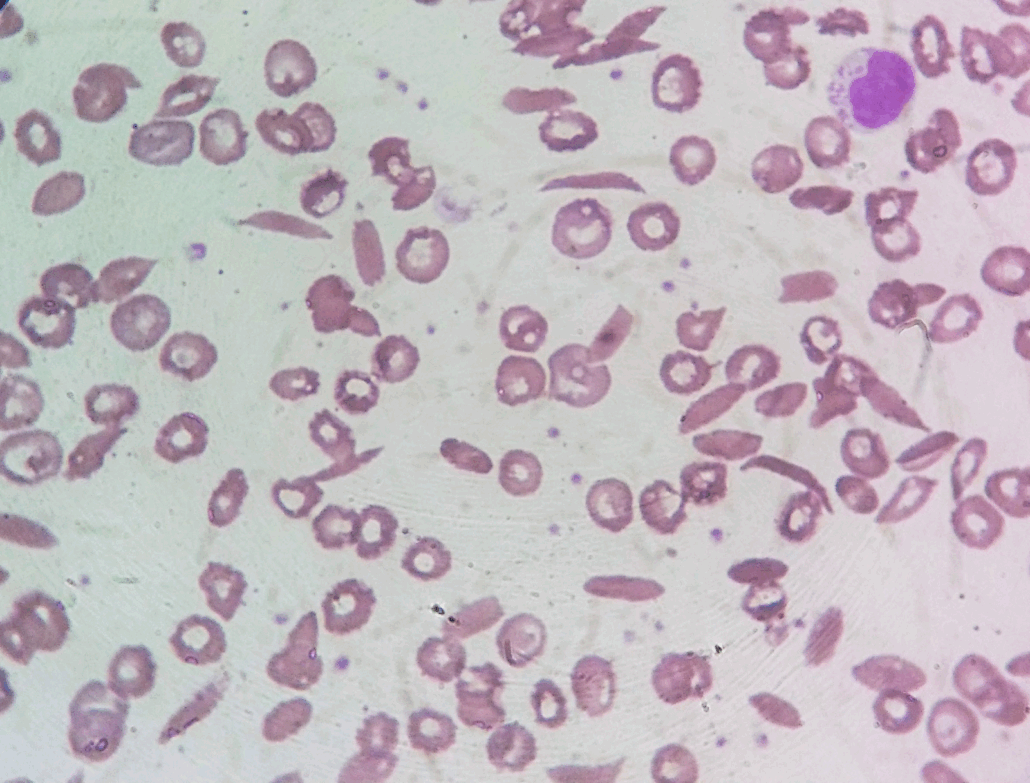

Anemia falciforme
A anemia falciforme é uma das hemoglobinopatias hereditárias mais relevantes no Brasil, especialmente devido à nossa história de miscigenação, que ampliou a distribuição da hemoglobina S em diferentes regiões e grupos populacionais. Caracterizada pela falcização das hemácias, essa condição provoca hemólise crônica e episódios de vaso-oclusão que podem comprometer múltiplos órgãos, resultando em dor intensa, bem como infartos teciduais e impactos significativos na qualidade de vida.

Relação entre Hemoglobina S e a Anemia Falciforme
A hemoglobina S (HbS) é uma variante anormal da hemoglobina que surge devido a uma mutação no gene da β-globina, onde ocorre a substituição do ácido glutâmico pela valina na posição seis da cadeia β. Essa alteração faz com que, em condições de baixa oxigenação, acidose ou desidratação, a HbS sofra polimerização, e então os glóbulos vermelhos tornem-se rígidos e passem a assumir o formato de foice. Como resultado, essas células não conseguem circular adequadamente pela microvasculatura.
Como identificar a Anemia Falciforme no laboratório
1. Hemograma
- Hemoglobina reduzida
- VCM normal ou levemente aumentado
- Leucocitose e plaquetas aumentadas podem aparecer
- Morfologia típica: drepanócitos (hemácias em forma de foice), policromasia, esquizócitos
2. Esfregaço de sangue periférico
- Drepanócitos
- Células alvo
- Microcitose em algumas variantes
Juntamente com Eletroforese de Hemoglobina e exames bioquímicos como: LDH e Bilirrubina indireta
Principais manifestações clínicas da anemia falciforme
As manifestações clínicas da anemia falciforme surgem principalmente pela falcização dos eritrócitos, que se tornam rígidos e aderentes, reduzindo o fluxo sanguíneo e provocando isquemia tecidual. Esse processo causa dor, infecções frequentes, anemia crônica e danos progressivos a órgãos como baço, pulmões e sistema nervoso central.
As crises dolorosas ocorrem quando há obstrução dos vasos, e costumam ser desencadeadas por desidratação, infecções, frio ou estresse. Além disso, a hemólise contínua contribui para sobrecarga do sistema cardiovascular, maior risco de infecções, crises aplásticas, síndrome torácica aguda, sequestro esplênico e acidente vascular cerebral, que podem evoluir rapidamente sem tratamento adequado.
Dessa forma, como não há cura definitiva para a maioria dos pacientes, o manejo depende da prevenção de complicações, do controle da dor, da hidratação, da vacinação e do uso de antibióticos e transfusões quando necessário. A compreensão dos mecanismos metabólicos e das manifestações clínicas permite intervenção precoce e melhora significativa da qualidade de vida.
Conclusão
A anemia falciforme, embora hereditária e amplamente conhecida, ainda exige atenção constante, pois a falcização das hemácias desencadeia crises vaso-oclusivas, dor intensa e episódios hemolíticos que variam entre os pacientes. Por isso, o laboratório torna-se essencial tanto para o diagnóstico quanto para o acompanhamento, já que exames como hemograma, eletroforese de hemoglobina, contagem de reticulócitos e marcadores de hemólise permitem identificar complicações precocemente e orientar condutas mais seguras. Assim, a interpretação criteriosa desses parâmetros não apenas apoia decisões clínicas, mas também contribui diretamente para reduzir riscos, prevenir agravamentos e melhorar a qualidade de vida do paciente falcêmico.
Como o domínio da doença falciforme eleva seu nível como analista clínico
A interpretação correta das alterações da doença falciforme, desde a identificação de hemácias falcizadas até a avaliação dos marcadores de hemólise e das complicações associadas, é uma das competências mais importantes na rotina hematológica, pois evita erros na condução clínica, antecipa riscos e garante maior segurança ao paciente.
Se você quer aprofundar esse tipo de conhecimento, desenvolver segurança e se tornar referência na área, a Pós em Hematologia Laboratorial do INML foi criada exatamente para isso, para formar profissionais capazes de interpretar, validar e raciocinar clinicamente com autonomia e excelência.
O próximo passo de todo analista que deseja ter mais segurança na bancada
Todo analista que busca se destacar e se tornar um profissional mais atualizado, capacitado e qualificado para o mercado de trabalho precisa considerar uma pós-graduação.
Um profissional com especialização é valorizado na área laboratorial; esse é um fato inegável.
Unimos o útil ao agradável ao desenvolver uma pós-graduação em Hematologia Laboratorial e Clínica.
Para aqueles que procuram a comodidade de uma pós-graduação 100% online e ao vivo, sem abrir mão da excelência no ensino, temos a solução ideal.
Nossa metodologia combina teoria e prática da rotina laboratorial, garantindo um aprendizado efetivo.
Contamos com um corpo docente altamente qualificado, com os melhores professores do Brasil, referências em suas áreas de atuação.
No Instituto Nacional de Medicina Laboratorial, temos apenas um objetivo: mais do que ensinar, vamos tornar VOCÊ uma referência.
Toque no botão abaixo e conheça a pós-graduação em Hematologia Laboratorial e Clínica.
QUERO CONHECER TODOS OS DETALHES DA PÓS-GRADUAÇÃO
Referências
SOUZA, Janaina Martins de; ROSA, Patrick Elan Lemos; SOUZA, Roberta Lemos; CASTRO, Geane Freitas Pires de. Fisiopatologia da anemia falciforme. Revista Transformar, 2016.
PAIVA E SILVA, Roberto B. de; RAMALHO, Antonio S.; CASSORLA, Roosevelt M. S. A anemia falciforme como problema de saúde pública no Brasil. The sickle cell disease as a Public Health problem in Brazil.
SOUSA, Guilherme Henrique Miranda; FONSECA, Iza Natalia Silva; MIRANDA, Kellyane de Sousa; HORACIO, Wanderson Ferreira; OLIVEIRA, Mirian Cristina de. Anemia falciforme: Sickle Cell Disease. Revista Ibero-Americana de Humanidades, Ciências e Educação – REASE, São Paulo, v. 7, n. 11, nov. 2021



